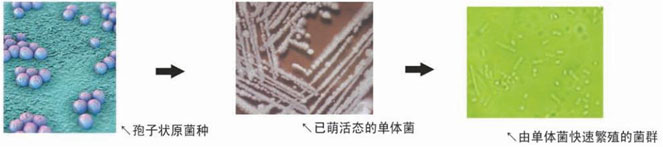
1656492805821264.jpg 1532490563214470.jpg

在線(xiàn)持續(xù)生物增效氨氮脫除技術(shù)是北京賽富威(SEL)環(huán)境工程技術(shù)有限公司科研人員在二十多年的環(huán)保技術(shù)實(shí)踐基礎(chǔ)上研發(fā)出來(lái)的新型廢水處理生物技術(shù)。該技術(shù)是在自主開(kāi)發(fā)的微生物培養(yǎng)器——定向馴化生物反應(yīng)器內(nèi)先將經(jīng)過(guò)篩選的特效氨氮脫除菌劑激活、定向馴化,使特效菌富集、放大,然后連續(xù)投加到廢水處理的好氧工藝段中,以提高系統(tǒng)處理氨氮去除效率的新技術(shù)。
本技術(shù)是北京賽富威環(huán)境工程技術(shù)有限公司的專(zhuān)利技術(shù)(專(zhuān)利類(lèi)型:發(fā)明專(zhuān)利證書(shū);專(zhuān)利號(hào):ZL201110197616.9),該技術(shù)及相關(guān)產(chǎn)品已申請(qǐng)國(guó)家發(fā)明專(zhuān)利。
技術(shù)介紹:
在線(xiàn)持續(xù)生物增效氨氮脫除技術(shù)為經(jīng)過(guò)篩選的特效微生物提供最佳生長(zhǎng)條件,使這些微生物從休眠的孢子狀態(tài)繁殖到對(duì)數(shù)生長(zhǎng)期,實(shí)現(xiàn)在生長(zhǎng)環(huán)境中達(dá)到最大極限濃度,并在氨氧化速率最高時(shí)投加到廢水生化處理系統(tǒng)中,從而提高系統(tǒng)對(duì)氨氮的處理效率和處理能力、降低出水氨氮指標(biāo)。

主要作用:
1、提升生化處理系統(tǒng)對(duì)氨氮沖擊的穩(wěn)定性和抗沖擊負(fù)荷能力; 2、實(shí)現(xiàn)生化系統(tǒng)對(duì)高氨氮廢水毒性沖擊后的快速修復(fù);
3、降低生化處理系統(tǒng)出水氨氮指標(biāo); 4、降低污水處理綜合運(yùn)行成本。

產(chǎn)品特點(diǎn):
賽富威在線(xiàn)持續(xù)生物增效氨氮脫除技術(shù)由特效生物菌劑和定向馴化生物反應(yīng)器兩種核心產(chǎn)品構(gòu)成。
特效生物菌劑:
所選擇的菌種為經(jīng)過(guò)篩選的、有針對(duì)性的硝化菌,主要應(yīng)用于:農(nóng)業(yè)/化肥生產(chǎn) 輕紡印染 石油化工 市政污水 食品加工 醫(yī)藥化工 畜牧行業(yè) 皮革加工 景觀河道 機(jī)械加工 礦業(yè)冶金 垃圾處置

定向馴化生物反應(yīng)器:
定向馴化生物反應(yīng)器是一個(gè)特制的微生物培養(yǎng)器,它可以完全模擬硝化菌生長(zhǎng)所需的條件,如:溫度、PH值、營(yíng)養(yǎng)成分、鹽都、含氧量等。使用時(shí)將硝化菌投入其中,使菌種在反應(yīng)器內(nèi)得以迅速繁殖、成熟、活化;然后將成熟高活性硝化菌投入廢水生化池內(nèi)。如此循環(huán)往復(fù)地為生化池補(bǔ)充充足的硝化菌,并確保投入菌群的高活性,使生化池運(yùn)行對(duì)氨氮的去除效率保持在高水平。
菌種在反應(yīng)器內(nèi)演變繁殖的過(guò)程:
賽富威定向馴化生物反應(yīng)器的作用:
1、 使生物由休眠的孢子狀態(tài)迅速被激活并快速增殖,實(shí)現(xiàn)在線(xiàn)生產(chǎn);
2、 對(duì)生物在待定環(huán)境中定向馴化,富集優(yōu)勢(shì)菌種,高效完成氨氮脫除;
3、 產(chǎn)出菌群數(shù)量大,高達(dá)108-109個(gè)/ml,活性高。
